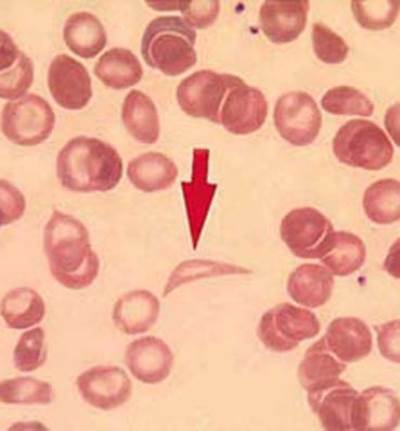
فقر الدم المنجلي والتلاسيميا .. هل حدث «ثورة» في علاجهما؟

أضرار فقر الدم وطرق الوقاية منه
فقر الدم "الأنيميا" حالة مرضية قد يشعر البعض أنها بسيطة ولا تؤدى إلى أى مضاعفات غير الدوخة والشحوب، فيهملون علاجها ولا يهتمون على الرغم من المشكلات التى قد تسببها، لذلك نقدم لك أضرار فقر الدم على الجسم، وفقا لما ذكره موقع "mayoclinic" الطبى.
أضرار فقر الدم
- التعب الشديد عندما يكون فقر الدم حادا، فقد يصل بك إلى عدم إمكانية إكمال المهام اليومية.
- مضاعفات على الحمل: فقد تكون النساء الحوامل المصابات بفقر الدم الناجم عن نقص حمض الفوليك أكثر عرضة لمضاعفات مثل الولادة المبكرة.
- مشكلات قلبية: فقر الدم يمكن أن يؤدى إلى ضربات القلب السريعة أو غير المنتظمة (عدم انتظام ضربات القلب)، لأن هذا الأمر يجعل قلبك يضخ المزيد من الدم لتعويض نقص الأوكسجين فى الدم، وهذا يمكن أن يؤدى إلى تضخم القلب أو قصور القلب.
- الموت: فقر الدم المنجلى يمكن أن تكون مضاعفاته خطيرة وتهدد الحياة، وفقدان الكثير من الدم يؤدى بسرعة إلى فقر الدم الحاد، والذى يكون شديدا ويمكن أن يكون قاتل.
طرق الوقاية من فقر الدم
ولا يمكن منع العديد من أنواع فقر الدم، ولكن يمكن تجنب فقر الدم الناجم عن نقص الحديد، من خلال التعامل بتوفير نظام غذائى يتضمن مجموعة متنوعة من الفيتامينات والمواد المغذية، بما فى ذلك:
- حديد، وتشمل الأطعمة الغنية بالحديد لحوم البقر واللحوم الأخرى والفاصوليا والعدس والحبوب المقواة بالحديد والخضروات الورقية الداكنة والفاكهة المجففة.
- حمض الفوليك، ويمكن العثور على هذه المغذيات فى الفواكه وعصائر الفاكهة والخضراوات الورقية الخضراء الداكنة، البازلاء الخضراء، والفاصوليا والفول السودانى، ومنتجات الحبوب مثل الخبز والحبوب والمكرونة والأرز.
- فيتامين ب 12، وتشمل الأطعمة الغنية بفيتامين ب 12 اللحوم ومنتجات الألبان والحبوب المقواة ومنتجات الصويا.
- فيتامين C، الأطعمة الغنية بفيتامين ج تشمل الحمضيات والعصائر والفلفل والقرنبيط والطماطم والبطيخ والفراولة، وهذه العناصر تساعد على زيادة امتصاص الحديد.